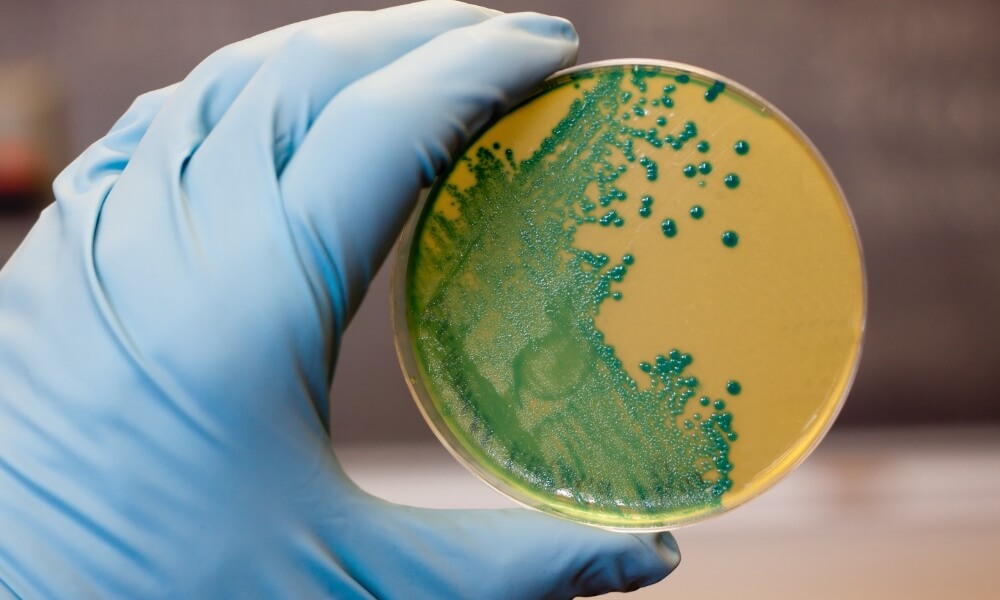
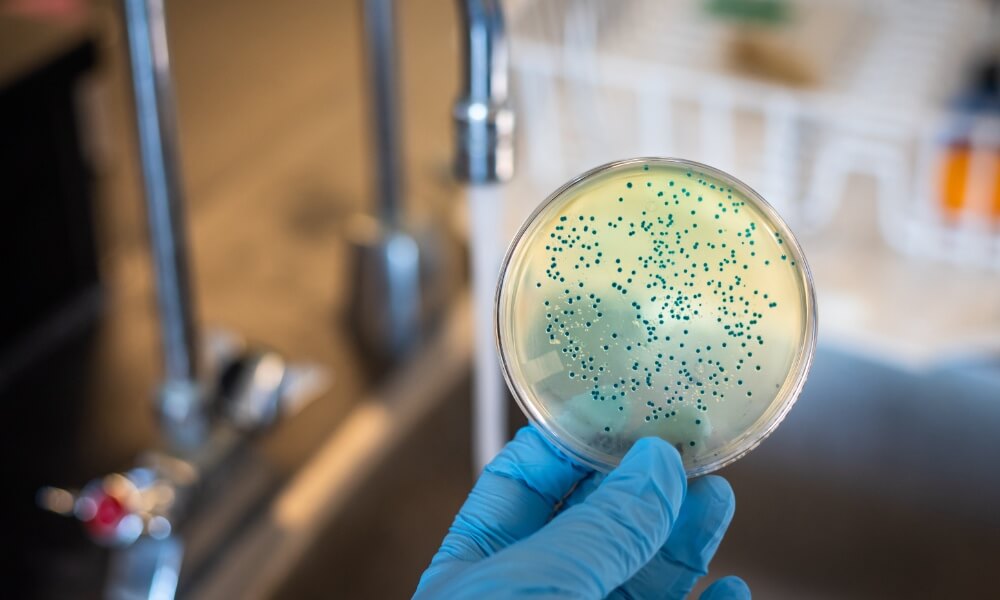

Maqneecon claims the knowledge and experience to provide fast and economical solutions to a variety of environmental and project management challenges.
Maqneecon is a 100% Canadian owned Company, provides variety of services including Project / construction management, environmental consulting for hazardous materials testing, inspection and abatement including asbestos and mould. Workplace Hazards identification, evaluation and control, Workers Exposure Assessment, Indoor Air Quality testing, Legionilla sampling, Drinking water and wastewater sampling.
Our professionals have comprehensive experience, with thorough knowledge of regulatory requirements, demonstrated success in planning, execution strategy and project management, to provide fast turn-around and practical engineering solutions of the highest standards to our clients.
Our highly alert team of engineers stand by you in emergencies and work like your own team to provide the solution you need.